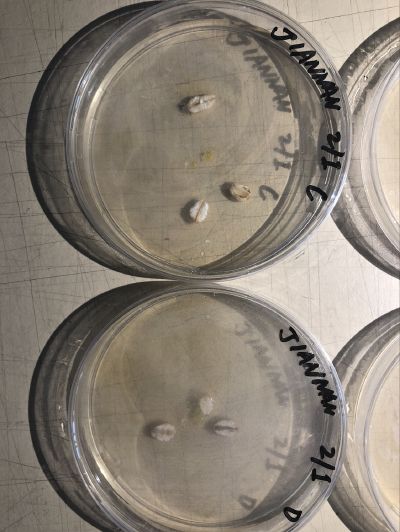
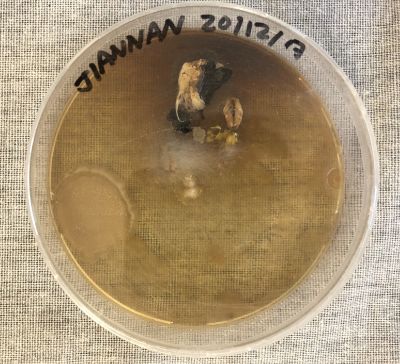

15/12/2017---experiment 1: start with waking up the slime molds
To have better samples to build the art installation, try to wake up old slime molds samples by growing them in the medium.
four samples:
A-normal medium(pure agar, salt, yeast, water..)+8-10 pieces of cereals
B-normal medium
C&D-normal medium+wet and old filter paper
samples are kept in dark lockers under 20 degrees
20/12/2017---experiment 2: waking up new slime molds samples from Sinan
samples from the last experiment failed.
Sample A was seriously contaminated. Nothing happened in sample B, C, &D
reason could be too much cereals or others
repeat the experiment with 3 more samples:
all in same condition: medium(Compound agar, water...)+1 piece of cereal
samples are kept in dark lockers under 24-26 degrees
21/12/2017---Update on experiment 2: bacteria
the samples look like contaminated by some bacteria in the middle
23/12/2017---Update on experiment 2: failed
the samples are contaminated and slime molds didn't wake up
reasons could be the temperature was too warm for the slime molds, food was too little and it was not humid enough inside the mediums
02/01/2018---experiment 3: grow new samples(from sinan) under suitable temperature
repeat the experiment with 4 more samples:
all in same condition: medium(Compound agar, water...)+3 pieces of cereal
A-sealed and kept on a shelf, 20 degrees;
B-not sealed and in a locker, 22 degrees;
C-sealed and kept in a locker, 22 degrees;
D-not sealed and kept on a shelf, 20 degrees.
08/01/2018---Update on experiment 3: possibly slime molds once woke up but died afterwards
all the samples are contaminated to some extend, but sample B shows similar trace of growing slime molds according to the shape
I will try this sample again and another ones with new humid filter papers and wood chips(which i searched online are good mediums for slime molds)
got the sections of the human brain model, 10 layers in total
10/01/2018---Experiment 4: comparing mushroom and oat flakes as food, agar and filter paper as medium
after research on the growth of slime molds in lab, Sinan and i decided to try different food and medium.
it was suggested to use humid filter paper or wood chips as the living environment of slime molds. However it is not easy to get fresh and clean wood chips. but filter paper is quite easy to acquire in our lab. And slime molds in nature often take mushrooms as their main food. In this case we would like to see if there would be any changes after we use different medium and food.
To provide enough space for mushroom and slime molds, i had 2 large petri dishes. I also prepared 2 normal sized petri dishes to make a comparison.
A-medium: agar, food: oat flakes;
B-medium: humid filter paper, food: oat flakes;
C-medium: agar, food: mushroom slices;
D-medium: filter paper, food: mushroom slices.
All the samples were taken home and kept in dark environment, under 24 degrees. The samples with filter papers were filled with drops of water every day to keep them humid.\
12/01/2018---Update on experiment 4
After 2 days' growth, the samples with agar show different levels of contamination.
On the contrary, there is nearly no change in the samples with filter papers, no contamination, no growth of slime molds.
In the meantime, I cut a 2mm thick plexiglass in to 70mm*70mm square pieces to build my prototype.
17/01/2018---Update on experiment 4 and experiment 5
Sample A and C are contaminated but there is a little piece of slime molds growing in sample C.
Sample B is contaminated by some white furry molds which grew from the oat flakes. Sample D has no obvious change inside the petri dish.
At the same time of this experiment, i also checked some old samples to see if there is any surprising progress. and i found a sample from 2 weeks ago has some suspected slime molds in it.
According the result i think it is better to keep using agar as the medium, and feeding slime molds with oat flakes, since there's no big influence the filter paper brought and mushrooms were not consumed much.
To proceed i take Mi ga's advice that i could feed more food to the successful samples and meanwhile use these samples to grow more. I put more oat flakes into sample C and the old sample.
Then Sinan and i picked up slime molds from these two and grow more. i have 4 new samples. Just to try to get more slime molds. so all the samples are in same medium and environment, fed by same food.
24/01/2018---Update on experiment 5 and plan on how to proceed
Unfortunately, all the samples fed with oat flakes were severely contaminated because of the oatmeals going bad themselves.
After this final experiment, i had a meeting with the class. Because of the short time we have for this semester, professor suggested me to analyze the success and failure on different samples, trying to find out why slime molds cannot grow well in winter. He encouraged us to research more and if it's possible, grow more samples in march. we might get different results.
The point of this project is not to build an art work, but to research on organisms and get to know them by experiments and reading articles. So the prior goal is to have my own understanding of slime molds.